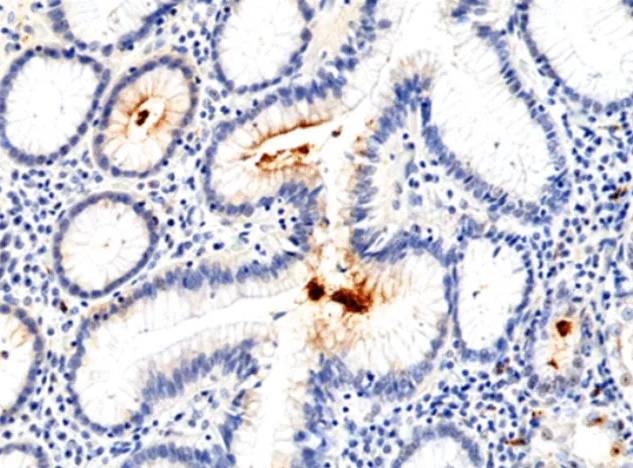

幽门螺杆菌是引发胃炎、胃溃疡的最常见致病菌......
在全球约半数人群感染幽门螺杆菌(Helicobacter pylori, H.pylori)的背景下,精准检测与深入研究成为对抗这一“胃健康杀手”的关键。RevMAb针对幽门螺杆菌推出多款高特异性兔单克隆抗体,覆盖H.pylori关键抗原靶点,为科研探索与临床诊断提供有力支持。今天,我们就来详细解读这些精准打击H.pylori的核心产品。
一、RevMAb 幽门螺杆菌抗体产品:靶向关键抗原,性能优异
RevMAb推出的幽门螺杆菌相关产品均为兔单克隆抗体,具有特异性强、灵敏度高、批次稳定性好的优势,为科研机构与诊断试剂企业提供高性价比选择。所有克隆均适配 ELISA 检测方法,部分克隆还可满足 IHC 等多种检测场景需求,可精准识别H. pylori不同毒力因子与功能蛋白,满足多样化研究与应用需求。
1. 核心产品清单与靶点特性
2. 产品核心优势:为何选择 RevMAb 的兔单克隆抗体?
● 高特异性与灵敏度:兔单克隆抗体相比鼠单克隆抗体,对H. pylori抗原的识别位点更丰富,交叉反应少,避免与空肠弯曲菌等类似细菌的干扰,ELISA检测中最低可识别0.0002 μg/ml的抗原(数据源自产品检测曲线),满足低浓度样本检测需求。
● 适配多场景应用:不仅可用于科研领域的H. pylori毒力因子研究、炎症机制分析,还能作为核心原料,支撑临床诊断试剂包括ELISA试剂盒的开发,覆盖“科研-试剂-检测”全链条。
● 靶点覆盖全面:从H. pylori存活关键的尿素酶、致病核心的HP-NAP,到定植相关的OMP, 再到广谱全菌抗原,全面覆盖H. pylori检测与研究的核心靶点,无需多品牌采购,降低实验成本。
二、市场现状:Hp检测需求旺盛,抗体试剂成核心支撑
根据QYResearch数据,2024年全球幽门螺杆菌筛查性检测市场规模约4.80亿美元,预计2031年将达6.53亿美元。中国作为H. pylori高感染率国家,是全球核心市场之一,随着胃癌早筛和体检意识提升,市场需求激增。RevMAb的H. pylori抗体产品作为H. pylori检测的上游核心原料,直接受益于下游市场增长:一方面,临床诊断试剂企业,如开发尿素呼气试验试剂盒、粪便抗原检测试剂盒等对高稳定性抗体的需求旺盛,为产品提供长期市场空间,另一方面,科研机构对Hp毒力因子、耐药机制的研究需求增加,但多数企业聚焦成品试剂盒,而RevMAb专注于高纯度抗体原料,填补了高精度科研级抗体的需求空白,针对OMP、HP-NAP等细分靶点的特异性抗体较少,RevMAb的多款不同克隆抗体组合可满足科研机构对“靶点细分研究”的需求,避免同质化竞争。
三、科研现状与前景:H. pylori靶点研究热度高,抗体是关键工具
1. 当前科研焦点:围绕“致病机制 + 耐药性”展开
早在1994年,国际癌症研究机构(IARC)将幽门螺杆菌列为Ⅰ类致癌因子,其科研方向主要集中在两大领域:
● 致病机制研究:HP-NAP如何激活炎症反应、OMP 如何介导H. pylori黏附、尿素酶如何帮助H. pylori在胃酸中存活,这些靶点的功能解析是当前热点。RevMAb的HP-NAP、OMP、尿素酶抗体,可直接用于蛋白表达检测、免疫共沉淀(IP)、免疫组化(IHC)等实验,助力机制阐明。
● 耐药性研究:我国H. pylori对克拉霉素耐药率已达50%,对甲硝唑耐药率超60%,科研机构正通过分子检测,如PCR分析耐药基因(23S rRNA 基因突变),而 RevMAb 的抗体可用于耐药菌株的分型检测,通过OMP表达差异区分耐药菌株,辅助耐药机制研究。
2. 未来科研方向:疫苗开发与精准治疗
抗生素是目前治疗幽门螺杆菌感染最常见和最有效的方法,然而,世界各地的抗菌素耐药性已成为一大挑战。迄今为止,临床上依然没有一款成熟的幽门螺杆菌疫苗上市,因此,探索疫苗研发新策略成为预防和治疗幽门螺杆菌感染的关键。
目前全球首个获得新药证书的口服重组幽门螺杆菌疫苗——口服重组尿素酶B疫苗,保护效率仍需提升,后续科研将聚焦多抗原联合疫苗,如尿素酶+ HP-NAP+OMP,而RevMAb的多靶点抗体可用于疫苗免疫原性检测,如评估疫苗诱导的抗体是否能识别H. pylori核心抗原,为疫苗研发提供支撑。
四、临床应用:从检测原料到疾病防控,抗体的间接价值
RevMAb的抗体虽不直接用于临床检测,但作为核心原料,支撑多种临床检测方法的开发,间接助力H. pylori感染的精准防控:
● 尿素酶抗体:用于快速尿素酶试验(RUT)试剂开发,胃镜检查时可即时判断H. pylori感染,帮助医生现场制定治疗方案;
● OMP/HP-NAP 抗体:用于ELISA试剂盒开发,检测患者血清或粪便中的 OMP/HP-NAP 抗原,评估感染致病性,如 HP-NAP 高表达提示炎症风险高;
● 广谱抗H. pylori抗体:用于粪便抗原检测试剂开发,适合儿童、老人等无法配合尿素呼气试验的人群,提升检测覆盖率。
根据北京天坛医院数据,H. pylori感染与90%以上的十二指肠溃疡、70%-80%的胃溃疡相关,且可使胃癌风险增加5.9倍,RevMAb 的抗体通过支撑精准检测,帮助尽早发现感染,减少严重并发症的发生,具有重要的公共卫生意义。
RevMAb 抗体——H. pylori研究与检测的“得力助手”
在 Hp 感染防控需求日益迫切的背景下,RevMAb的幽门螺杆菌兔单克隆抗体凭借靶点全、特异性高、适配场景广的优势,既为科研机构提供了解析H. pylori致病机制、开发疫苗的关键工具,也为诊断试剂企业提供了高稳定性的原料支撑,有望在快速增长的H. pylori检测市场中占据重要地位。
未来,随着H. pylori精准医疗,如耐药基因检测、个性化治疗的推进,对细分靶点抗体的需求将进一步增加,RevMAb的产品矩阵也将持续为消除H. pylori感染、降低胃癌风险贡献力量。
▌想了解更多病理抗体产品技术信息?欢迎访问 RevMAb 官网或联系 AREX 技术团队,获取抗体试剂支持方案。
恩瑞科(杭州)生物科技有限公司
杭州西湖区西溪路525号A楼西区315室 310013
400-886-0853
www.arexbio.com
info@arexbio.com
固话1:0571-8708-2185
固话2:0571-8708-1890
Post time: 2026-01-15 17:44:04
- Previous: 12 倍增长!细胞因子动态监测赋能 CGT IIT 研究新范式
- Next: “P家族”抗体集合:抗癌与信号通路研究的明星探针
